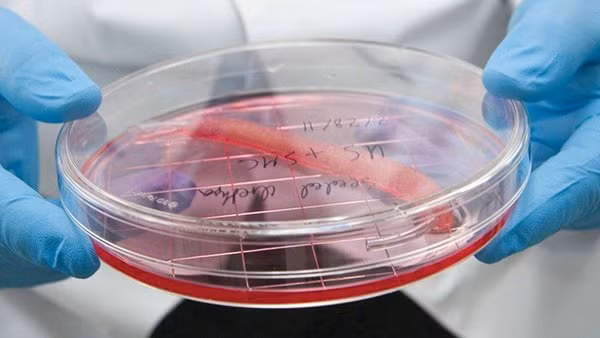
Máy in sinh học có thể giúp tạo ra những bộ phận cơ thể có thể thay thế bộ phận bị hỏng, như niệu đạo trong hình.

Anh Luke Massella, hiện 27 tuổi, là một trong khoảng mười người còn sống với một bàng quang thay thế được trồng từ các tế bào của chính mình. Khi ra đời, anh mắc phải chứng nứt đốt sống, để lại một khoảng trống trong cột sống của mình. Năm 10 tuổi, Massella đã trải qua hàng chục ca phẫu thuật và có thể đi lại được trong sự ngạc nhiên của bác sĩ.
Cơ hội sống mới
Nhưng sau đó một bàng quang bị hỏng khiến thận của anh gặp vấn đề. “Tôi đối mặt với khả năng có thể phải chạy thận nhân tạo trong suốt quãng đời còn lại. Tôi sẽ không thể chơi thể thao và có cuộc sống bình thường”, anh Massella nhớ lại. Hy vọng của Massella xuất hiện sau khi Tiến sĩ Anthony Atala ở Bệnh viện Nhi Boston (Mỹ) lấy một mẩu nhỏ bàng quang của Luke và phát triển thành một cái mới trong phòng thí nghiệm trong quá trình kéo dài hai tháng.
Sau đó, trong cuộc phẫu thuật kéo dài 14 giờ, ông Atala đã thay thế bàng quang bị khiếm khuyết bằng cái mới.
“Những gì diễn ra khá giống với cấy ghép bàng quang nhưng bàng quang mới được phát triển từ tế bào của chính tôi nên nguy cơ đào thải không xảy ra”, Massella cho biết. Sự đào thải xảy ra khi hệ thống miễn dịch của cơ thể tấn công tế bào cấy ghép đến từ một cơ thể khác. Sử dụng mô được trồng từ tế bào của bệnh nhân giúp chống lại tác dụng này.
 |
| Máy in sinh học của công ty Cellink. |
Sau này, Massella có thời gian làm huấn luyện viên đấu vật ở các trường công lập tại bang Connecticut (Mỹ) và hiện điều hành các sự kiện trong ngành trang sức. “Tôi đã có thể sống một cuộc sống bình thường sau khi được phẫu thuật”, anh nhận định. Từng trải qua 17 cuộc phẫu thuật trước khi lên 13 tuổi nhưng từ đó đến giờ anh không còn phải lên bàn mổ thêm lần nào nữa.
Công việc của bác sĩ Atala liên quan đến in sinh học, sử dụng máy in 3D được điều chỉnh để sản xuất mô sinh học. Nhóm nghiên cứu của ông đã phát triển được “tám mô dựa trên tế bào có thể được vào cơ thể bệnh nhân” trong phòng thí nghiệm, trong đó có da, niệu đạo, sụn… Các bộ phận này trong quá trình thử nghiệm lâm sàng với hy vọng được Cục Quản lý Thực phẩm và Dược phẩm Mỹ (FDA) bật đèn xanh.
“Bạn cần phải biết cách chế tạo các bộ phận này bằng tay, sau đó máy in sinh học giúp mở rộng quy mô phát triển chúng”, ông Atala, hiện là Giám đốc Viện nghiên cứu y học tái sinh Wake Forest ở bang Bắc Carolina (Mỹ), nhận định. Nói cách khác, in sinh học sẽ cho phép các cơ quan nội tạng được làm ra chính xác, nhất quá và có chi phí hợp lý. Theo ông, những cấu trúc phẳng như da là dễ in nhất. Phức tạp hơn là cấu trúc hình ống, như mạch máu và niệu đạo, rồi đến cơ quan rỗng không có cấu trúc hình ống, như bàng quang. Khó nhất vẫn là các cơ quan nội tạng rắn, như tim, phổi, thận… với số lượng tế bào trên mỗi cm lớn hơn nhiều. Đối với những bộ phận cơ thể có cấu trúc phức tạp cao như thế, máy in sinh học mang đến sự chính xác cao hơn bàn tay con người.
|
| Máy in sinh học có thể giúp tạo ra những bộ phận cơ thể có thể thay thế bộ phận bị hỏng, như niệu đạo trong hình. |
Những bước đột phá
Ngành in sinh học đã cất cánh sau một phát hiện đột phá của hai nhà khoa học Shinya Yamanaka và John Gurdon, giúp mang lại cho họ giải Nobelnăm 2012. Theo công trình nghiên cứu của họ, các tế bào bình thường trưởng thành giờ có thể được tái lập trình để tạo ra tế bào gốc - gọi là tế bào gốc đa năng cảm ứng (IPSC).
IPSC có thể được sử dụng để tạo ra bất kỳ tế bào nào khác trong cơ thể. “Rất nhiều điều đã xảy ra trong vài năm qua”, ông Steven Morris, Giám đốc điều hành công ty khởi nghiệp Biolife4d (Mỹ) trong lĩnh vực in sinh học, nhận định.
Công ty của ông Morris đang nỗ lực in sinh học một trái tim bằng cách sử dụng IPSC trong năm tới. Phiên bản ban đầu sẽ nhỏ hơn tim thật nhưng có thể giúp các công ty dược phẩm không cần phải thử nghiệm thuốc trên động vật. Về lâu dài, việc in sinh học cơ quan nội tạng người từ chính tế bào của bệnh nhân có thể giúp giải quyết được tình trạng thiếu hụt nguồn cung trong lĩnh vực cấy ghép trong lúc loại bỏ nhu cầu sử dụng thuốc chống thải loại.
 |
| Dù mới 10 tuổi vào năm 2001, Luke Massella đã phải trải qua nhiều cuộc phẫu thuật. |
Các máy in đặc biệt thậm chí có thể tái tạo các khối u ung thư, mang lại cho bác sĩ cơ hội kiểm tra liệu một phương pháp điều trị nào đó có hiệu quả đối với bệnh nhân hay không, ông Erik Gatenholm, Giám đốc điều hành công ty khởi nghiệp Cellink (Thụy Điển), dự báo công ty của ông đã được Liên minh châu Âu tài trợ 2,9 triệu đô la để chế tạo loại máy in mô hình những khối u này.
Chưa hết, ông Annop Friskopp, Phó chủ tịch phụ trách các hệ thống in ấn chuyên biệt tại hãng công nghệ HP (Mỹ), cho biết thêm máy in sinh học mang đến cách thức thử nghiệm nhanh chóng một loại kháng sinh mới xem nó có hiệu quả với một bệnh nhân nào đó hay không. Điều này có thể giúp giải quyết vấn đề kháng thuốc kháng sinh ngày một nghiêm trọng, tức sự trỗi dậy của loại siêu khuẩn mà kháng sinh truyền thống không thể tiêu diệt được. HP đang hợp tác với Trung tâm kiểm soát dịch bệnh Mỹ để triển khai máy in đặc biệt tại bốn phòng thí nghiệm khu vực ở Mỹ trong mùa thu năm nay.
 |
| Bác sĩ Ahu Arslan Yildiz cầm một khối u ung thư được tạo ra bằng in sinh học. |
Cũng như bất kỳ loại máy in nào, máy in sinh học cũng cần đến “mực sinh học”. Các phòng thí nghiệm tại trường đại học và công ty khởi nghiệp, như Cellink, đã phát triển được loại mực sinh học có thể được sử dụng với nhiều loại tế bào. Bà Ahu Arslan Yildiz, một nhà sinh hóa học đứng đầu một nhóm nghiên cứu tại Viện Công nghệ Izmir (Thổ Nhĩ Kỳ) nhận định những loại mực sinh học này ngày càng dễ xử lý trong lúc không độc hại.
Một bước đột phá khác đến từ Nhật Bản. Hầu hết quá trình in sinh học sử dụng một “giàn giáo” để giữ cố định tế bào. Đến một mức độ nào đó, tế bào bắt đầu tự tổ chức, lắp ráp và “giàn giáo” sau đó có thể được tháo dỡ - theo giải thích của ông Arnold Kriegstein, chuyên gia tại Trường Đại học California, San Francisco (Mỹ). Giờ đây, ông Koichi Nakayama, đến từ Trường Đại học Saga (Nhật Bản), đã tìm ra cách tạo mô 3D mà không cần đến giàn giáo và đang thử nghiệm phát minh này trên người.
Với những thành tựu nói trên, in sinh học đang tạo ra những bước tiến lớn và hứa hẹn mang đến cho nhiều người cơ hội sống mới.
Theo Thời báo Vi tính Sài Gòn
https://www.thesaigontimes.vn/279943/in-mo-nguoi-thoi-3d-.html







































